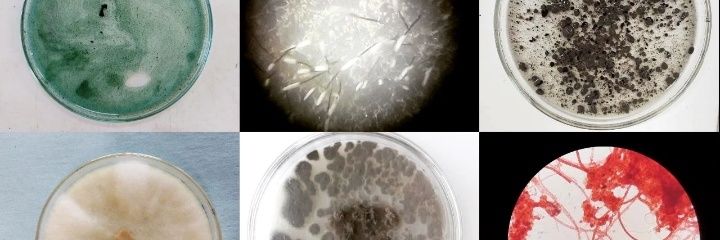
Cecilia Callejas banner

Cecilia Callejas
358 posts

Cecilia Callejas
@caiejas
Entusiasta de la Microbiologia en @bioproa / Docente @udelar / Participando en @investigauy
























¿Cuáles son las propuestas sobre Ciencia, Tecnología e Innovación en la campaña electoral 2024? Compartimos un análisis de los programas de los partidos y las/os distintas/os precandidatas/os, realizado por @GonzaloTancredi, Presidente de Investiga uy. Compartimos el link con el análisis completo: investiga.uy/_files/ugd/1d3… 📢 Importancia de la CTI para el desarrollo de Uruguay. Todos los partidos analizados (Frente Amplio, P. Colorado, P. Independiente, P. Nacional) coinciden en que la Ciencia, Tecnología e Innovación son claves para el progreso y la inclusión social. 🏛️ Gobernanza y planificación en CTI: Frente Amplio propone una nueva Ley de CTI y la creación de “una institucionalidad específica al más alto nivel gubernamental”. Cosse y Mieres plantean una Secretaría en la órbita de Presidencia. Delgado, Ojeda y Silva proponen la gestión y jerarquización y reforzamiento de la DICYT en la órbita del MEC. 💸 Inversión en I+D+i: Frente Amplio, Ojeda, Silva y Mieres apuntan a incrementar la inversión en I+D+i al 1% del PBI. Otros candidatos no plantean metas específicas. ¡Se requieren más fondos para impulsar la investigación e innovación en Uruguay! 🌱 Sectores estratégicos: Todos los programas que se plantean como prioritarios los sectores de las TICs (incluyendo la Robótica, y la Inteligencia Artificial), la Biotecnología y las Ciencias de la Vida, y las Energías renovables (incluyendo Hidrógeno Verde). 💡 Acciones específicas: En varios programas hay propuestas como apoyo a start-ups mediante incentivos fiscales, promover la compra pública innovadora por parte del Estado, la formación y atracción de talentos, reforzar los sistemas de becas y apoyo a los investigadores. Delgado, Ojeda y Silva desarrollan propuestas para el sector de innovación. 👩🔬👨🔬 Políticas de género y educación en CTI. Frente Amplio, Ojeda y Silva proponen acciones para promover la igualdad de género en STEM con programas, becas, e impulso a las niñas. El impulso de Ceibal como agencia de innovación educativa al servicio del sistema educativo está presente en todos los programas. Hay espacios para buscar amplios niveles de acuerdo que profundicen los compromisos anteriores, con la participación del sector político, académico y empresarial. Pasadas las elecciones internas, seguiremos conversando para concretar estos acuerdos.






